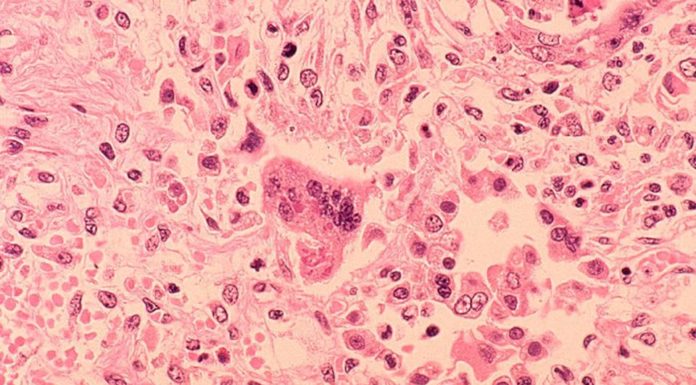
Morbillo – Cos’é il morbillo?

Il vaccino per la malaria fa notizia. La letteratura originale sulla teoria dell'immunità di gregge, a 50 anni dalla sua formulazione, contiene riflessioni specifiche sul vaccino antimalarico....
Chiarimenti essenziali sugli esami pre-vaccinali disponibili per avere un quadro realistico della loro effettiva utilità, a cura del Dott. Proietti e Dott. Serravalle (AsSIS).
Si...
Ufficialmente con quali criteri è consigliato introdurre un obbligo vaccinale secondo l'OMS? Ce lo spiega l'articolo "La strana fretta di rendere obbligatoria la vaccinazione anti varicella"...
Cos'è l'immunità di gregge e come funziona scientificamente? Esiste una soglia di copertura vaccinale critica univoca del 95%? L'effetto gregge è il movente invocato per imporre l'obbligo...
Un ascolto didattico per scoprire rimedi antichi e moderni per il morbillo, malanno contagioso tipico dell'infanzia, fino a poco tempo fa ritenuto importante per...
In Italia la riduzione della mortalità da morbillo è illustrata dal grafico pubblicato nello studio La mortalità dei bambini ieri e oggi realizzato da...
Il morbillo è una malattia infettiva acuta, altamente contagiosa, causata da un virus appartenente alla famiglia dei Parvomyxoviridae. Si trasmette per mezzo delle goccioline...